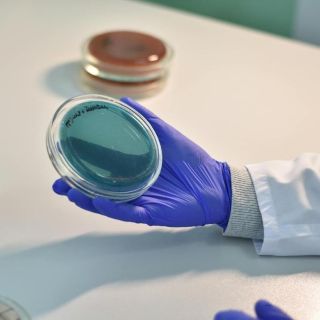

|
Newsletter AOGOI #423
06 Dicembre 2025
|
Notiziario settimanale dei ginecologi italiani
|
![]() |
| Aogoi informa | Politica | Regioni e Asl | Scienza |
![]() |
La lettera, a firma del presidente Fnomceo Filippo Anelli, chiede di inserire nel prossimo Decreto Milleproroghe anche il prolungamento della disposizione sullo “scudo penale”, altrimenti in scadenza il 31 dicembre. Tra le ragioni: la carenza di personale e l’aumento copioso della medicina difensiva. Lettera Fnomceo al Ministro Schillaci |
![]() |
Suicidio la principale causa, ma anche patologie cardiovascolari ed emorragia ostetrica. Il 42% dei decessi classificato come evitabile. L’Italia è uno degli otto Paesi europei dotati di un sistema avanzato di sorveglianza (ItOSS) che mira a ridurre le morti materne evitabili e a migliorare la qualità dell’assistenza alla nascita. |
![]() |
Lo afferma il rapporto della sorveglianza RespiVirNet, pubblicato oggi. L’incidenza totale delle infezioni respiratorie acute nella comunità, nella settimana dal 24 al 30 novembre, è stata pari a 10,4 casi per 1.000 assistiti (vs 8,96 nel bollettino precedente). Da inizio sorveglianza colpite 3,2 mln di persone. Nei bambini tra 0 e 4 anni l’incidenza più elevata. |
![]() |
I ricercatori della London School of Hygiene & Tropical Medicine e della City St. George’s University of London hanno analizzato 12 milioni di esami del sangue raccolti in 29 Paesi europei tra 2010 e 2019: le differenze più marcate riguardano gli over 74, specialmente uomini. |
![]() |
Nuovi dati mettono in luce l’ampia variabilità tra strutture ospedaliere e universitarie nella percentuale di ricoveri ordinari associati a DRG considerati ad alto rischio di inappropriatezza. Tra gli atenei, spiccano punte oltre il 21%. Un indicatore chiave per valutare l’efficienza delle degenze e l’uso corretto delle risorse. |
![]() |
I dati Agenas mettono in luce criticità profonde nel sistema dell’emergenza, con tassi di abbandono molto elevati in diverse strutture e percentuali significative di accessi che comportano tempi di attesa superiori alle 8 ore. Al Policlinco Tor Vergata di Roma un paziente su 4 attende oltre 8 ore prima di essere visitato. A Palermo al Ps Riuniti Villa Sofia–Cervello il 24,7% dei pazienti abbandona la struttura prima della visita. |
![]() |
Il primo appello registra percentuali di promossi bassissime, specialmente in Fisica. I dati pongono un rischio senza precedenti: che i posti disponibili in facoltà superino il numero di studenti effettivamente idonei a occuparli. |
![]() |
Aggiornamento 2025 delle Linee guida SIGO-AOGOI-AGUI sull’induzione del travaglio di parto (Integrazione alla revisione del Febbraio 2022), realizzato dalla Fondazione Confalonieri Ragonese. Il documento introduce modifiche puntuali su aspetti clinici e di sicurezza relativi alle diverse modalità di induzioni del travaglio, che rappresenta uno degli interventi più frequenti in ostetricia e interessa oggi circa un quarto delle donne che partoriscono in Italia. [Cont….] |
![]() |
Come sappiamo il protocollo ERAS è nato con l’obiettivo di garantire, dopo l’intervento, un recupero ottimale e un ritorno il più possibile precoce e sicuro alle attività quotidiane ed è sempre più utilizzato in chirurgia, anche in ginecologia.
Sono stati messi a punto due questionari volti a mappare a livello nazionale l’applicazione del protocollo ERAS in caso di taglio cesareo, nonché la diffusione della procedura del taglio cesareo gentile/dolce/family-centered…
|
![]() |
Disbiosi intestinale, stress ossidativo e neuroinfiammazione sono spesso coesistenti nelle donne con endometriosi, contribuendo alla cronicizzazione del dolore e alla ridotta risposta ai trattamenti. La correlazione tra infiammazione e disbiosi intestinale nell’endometriosi è un’area di ricerca sempre più approfondita. L’endometriosi è intrinsecamente legata a uno stato di infiammazione cronica sia sistemica che locale, alimentata da un’attivazione anomala del sistema immunitario e dalla produzione di citochine pro-infiammatorie come il TNF-α, l’IL-6 e l’IL-1 beta. |
![]() |
Nell’ultimo secolo abbiamo assistito a sorprendenti cambiamenti nella diffusione ed epidemiologia delle infezioni sessualmente trasmesse (IST), o ‘malattie veneree’, come venivano denominate fino a qualche decade fa.
Nella seconda metà del ‘900, grazie all’avvento degli antibiotici, è stato possibile ridurre grandemente l’incidenza delle due ‘malattie veneree’ maggiormente diffuse per via sessuale (sifilide e gonorrea) e questo ha indotto in qualche misura a considerare che questo tipo di patologie non costituisse più un problema da tenere in considerazione.
|
![]() |
Questo documento è stato redatto a seguito del Convegno “La vaccinazione in gravidanza. L’importanza della prevenzione primaria”, svoltosi presso il Senato della Repubblica in data 10.04.2024, promosso su iniziativa della Senatrice Castellone e organizzato in collaborazione con Fondazione Onda ETS e SIGO, patrocinato da AGUI, AOGOI, FNOPO, SIMG e SIN-Neonatologia e SITI…
|
![]() |
Guida pratica per professionisti sanitari
Coordinamento scientifico: Dott. Carlo Maria Stigliano
Una guida pratica e aggiornata in formato D&R (domande e risposte) per ginecologi e operatori sanitari, con informazioni su efficacia, sicurezza e indicazioni della vaccinazione anti-HPV.
|
![]() |
![]() |
La nostra rivista sta crescendo e da questo numero sarà distribuita anche in farmacia. Questo rende molto orgogliosa non solo Aogoi, con il suo Presidente, tutto il Direttivo nazionale, le Segreterie nazionale, regionali, provinciali e tutti noi ginecologhe, ginecologi che abbiamo creduto in questo progetto, ma anche tutti coloro che lo hanno reso possibile.
|
![]() |
La Fondazione Confalonieri Ragonese su mandato delle società scientifiche SIGO, AOGOI, AGUI, in collaborazione con AGITE, è lieta di pubblicare le raccomandazioni n.21 che rappresentano il prezioso risultato di un impegnativo lavoro di un gruppo, composto da numerose colleghe/i non solo del mondo ostetrico ma riconosciuti esperti dell’argomento, che con passione e gratuità ha dedicato tre anni di studio, incontri, scambio di opinioni ed analisi di una vasta letteratura scientifica. |
![]() |
Attivo fino al 9 dicembre 2025 |
![]() |
Attivo fino al 31 dicembre 2025 |
![]() |
Attivo fino al 31 dicembre 2025 |
![]() |
Attivo fino al 31 dicembre 2025 |
![]() |
Settembre – Dicembre 2025 Oncology ProfEssional Remote Academy – III EDIZIONE |
![]() |
5 – 6 Dicembre 2025 Sfide attuali e futuri orizzonti Responsabili scientifici: L. Bello, F. Bogliatto |
![]() |
11 – 12 dicembre 2025 Presidenti del Congresso: Dott. ssa Simona Pesce, Prof. Sergio Schettini |
![]() |
11 – 12 dicembre 2025 THE PELVIS AS A MOTHER – InternationaI Meeting |
![]() |
14 – 17 dicembre 2025 100° Congresso Nazionale SIGO |
|
|
|
| Questo messaggio è stato inviato alla tua email in ottemperanza al Decreto legislativo 196/03 da parte di WelfareLink.
Copyright 2025 © AOGOI. Tutti i diritti sono riservati | Privacy |